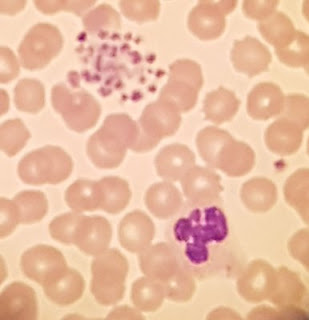

As I type this entry the blog has been visited over four hundred times in the last week.
During that time I (effectively) blagged an IBMS JBL exercise, saw some platelet clumps, did (seemingly) badly at a digital morphology exercise, did well at a simulated blood transfusion exercise and got two NEQAS exercises right. And in that time I also read all sorts of stuff from the nice people at Lablogatory, the American Society of Hematology, Oncology Central and Laboratory News (to list just a few) that weren’t relevant enough to warrant a mention.
I’d be
intrigued to know how much CPD other biomedical scientists have done n the same
time period. I suspect I don’t do any more (or less) than anyone else; I
just take a few minutes to write it down. Mainly because I live in terror of
being called up for audit.
I never
set out to make this blog “popular”, but it certainly seems to have
developed a following. I’d just like to take this opportunity to say to all my
followers that I do hope that you find this in some way useful. And do feel
free to comment on any of the posts on here – that would count as CPD for you…